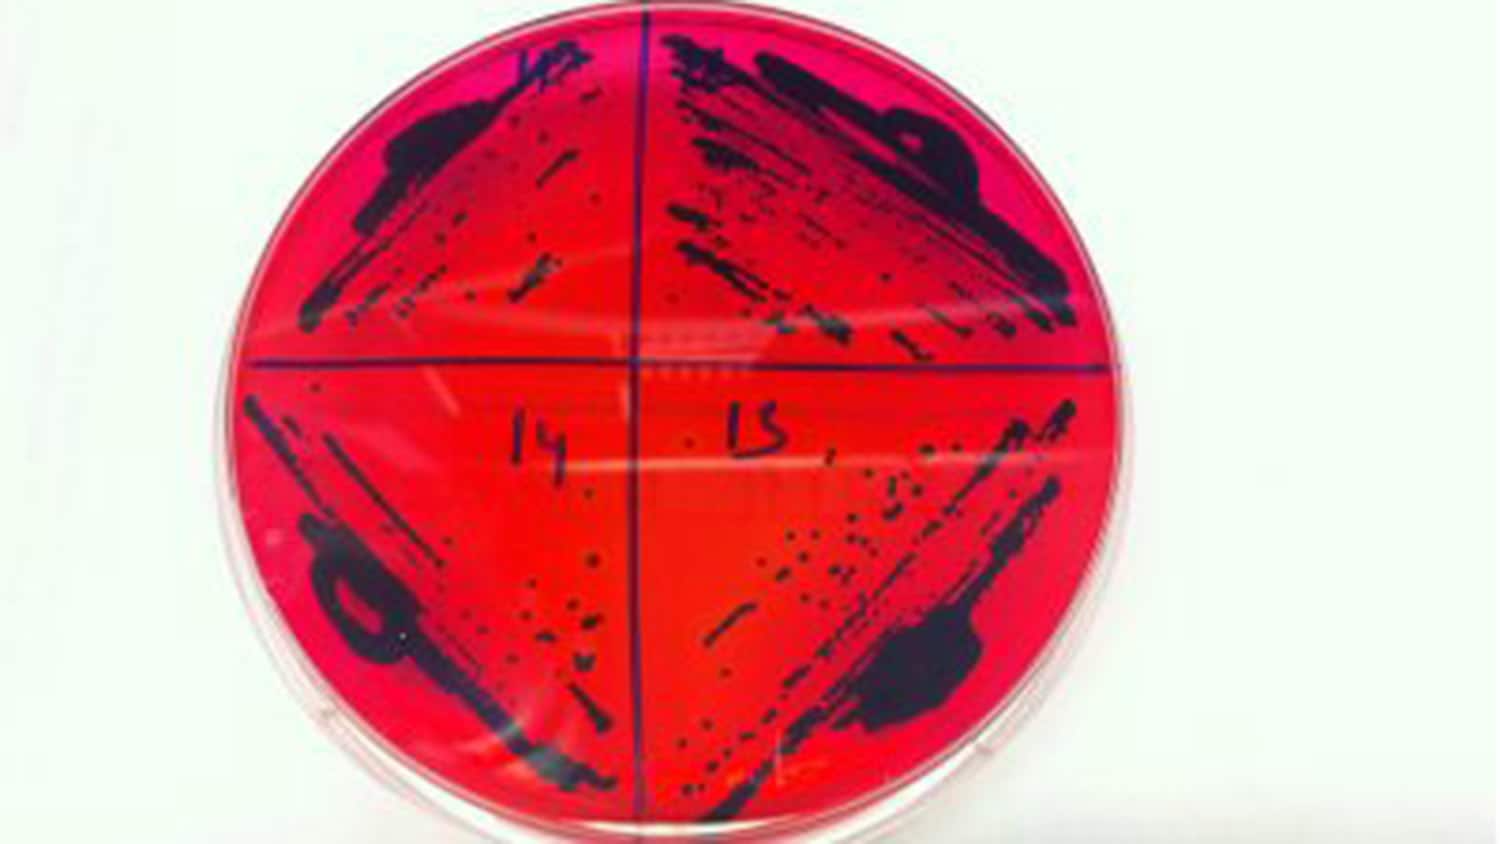

Researchers Sequence Genome of Drug-Resistant Salmonella Enteritidis Strain That Can Sicken Poultry
Researchers from North Carolina State University sequenced the genome of a virulent Salmonella Enteritidis strain that sickened two poultry flocks in consecutive years and found that it was both antibiotic resistant and could potentially infect humans.
Salmonella colonies
Salmonella colonies
Researchers from North Carolina State University sequenced the genome of a virulent Salmonella Enteritidis strain that sickened two poultry flocks in consecutive years and found that it was both antibiotic resistant and could potentially infect humans. Characterizing the strain, designated SE_TAU19, will aid public health agencies in tracing outbreaks and preventing exposures.
There are two species of Salmonella, and one of these, Salmonella enterica, is implicated in human disease. S. enterica contains over 2,500 serovars, or groups of bacteria, many of which can cause disease in humans. Salmonella serovar Enteritidis (SE) is most frequently associated with poultry and is the leading cause of human illness globally.
Most human Salmonella infections are foodborne in origin, and many animals – such as chickens – can harbor the pathogen without becoming sick themselves. The ability of SE_TAU19 to cause clinical disease in poultry interested Grayson Walker, a combined DVM and Ph.D. student in Luke Borst’s laboratory at NC State’s College of Veterinary Medicine and first author of a paper describing the research.
“We usually think of Salmonella as harbored by chickens without harming them; however, this strain was virulent and actually made them sick,” Walker says. “We also know that Salmonella likes to stick around. This strain killed broiler chickens throughout the growing period and recurred one year later in a different flock. So, we decided to sequence the genome and see which resistance and virulence features made the strain unique.”
The team sequenced the genome of the strain and found that it included seven antimicrobial resistance genes, 120 virulence genes, and a large virulence plasmid. Plasmids are “swappable” genetic elements that can be exchanged between strains to make them more antibiotic resistant or infectious.
“While we cannot say that it is a ‘new’ strain of Salmonella, we can say that not only is this strain deadly to poultry, antibiotic resistant and infectious, but also that it could infect humans,” Walker says. “The good news is that by sequencing the genome we now have data that could help pinpoint the origin of and contain any future outbreaks.”
Publication: Grayson K. Walker, et al., Genomic characterization of a nalidixic acid-resistant Salmonella Enteritidis strain causing persistent infections in broiler chickens, Frontiers in Veterinary Science (2023). DOI: 10.3389/fvets.2021.725737.
Original Story Source: North Carolina State University

 Alerts Sign-up
Alerts Sign-up